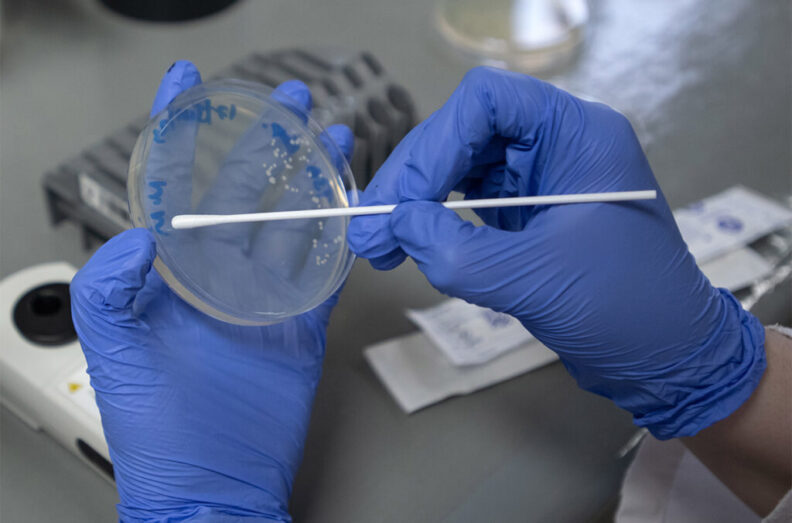

With $1.52 million in funding from the Centers for Disease Control and Prevention in 2023, Washington State University continues to be a leader in antimicrobial resistance research.
The funding is the second most of any university in the Western United States and ranks ninth nationally among public educational institutions.
“Most antimicrobial resistance does not arise in the United States, but because WSU has such a large global footprint, we’re able to assess and understand what is happening in other countries and work to stop those drug-resistant bacteria from being imported into the U.S.,” said Guy Palmer, WSU’s senior director of global health.
Antimicrobial resistance, recognized by the CDC as an urgent global public health threat, occurs when bacteria develop the ability to resist the drugs designed to kill them, which allows infections to persist.
According to the CDC, antimicrobial resistance killed nearly 5 million people in 2019. In the U.S., more than 2.8 million antimicrobial-resistant infections occur each year.
To combat this, WSU leads research projects in Guatemala and Kenya as well as in Washington state.
In Guatemala, researchers are examining samples from livestock, companion animals, milk, and drinking water to better understand the transmission of antimicrobial resistant bacteria as it relates to community sanitation and hygiene.
In Kenya, researchers are surveying drinking water and its sources as well as other water sources for antimicrobial-resistant Escherichia coli to improve prevention measures.
WSU researchers in both countries are part of the CDC’s Antibiotic Resistance in Communities and Hospitals (ARCH) program, studying the burden and risk factors for colonization with antimicrobial-resistant bacteria. They also assess health and economic impacts of colonization with resistant bacteria.
At WSU Pullman, associate professor and infectious disease epidemiologist Eric Lofgren is building up the antimicrobial resistance workforce through the Resistance Epidemiology Modeling Initiative (REMI). The initiative is funded by the CDC and supports the research of three pre-doctoral fellows at WSU who use computational tools and mathematical methods for modeling the spread of pathogens in health care.
WSU is also part of a new Intermountain West infectious disease surveillance program that monitors antimicrobial-resistance threats.